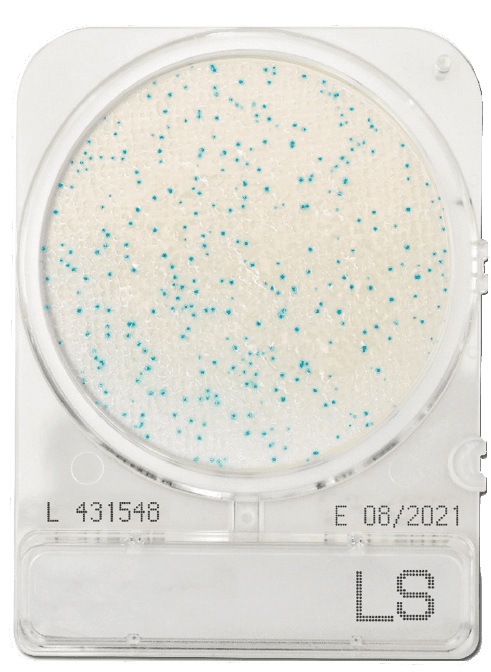

Listeria species are found in many environments such as soil, water, decaying vegetation, and animals. Certain species, such as Listeria monocytogenes, can survive refrigeration and other food preservation methods.
Listeria species can be transferred into the food chain when food is harvested / stored and can remain as a contaminant throughout the food production process. This requires continuous monitoring of raw materials, processed product, and the food production environment.